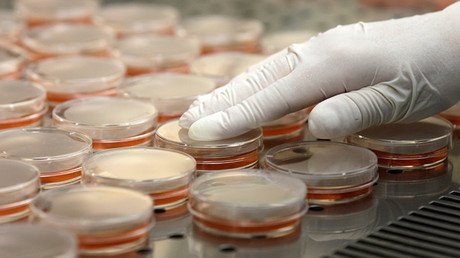
¿Plaga inminente?: El aumento de las 'superbacterias' indias puede "impactar en todo el mundo"

Hace siglos, los príncipes indios se bañaban en el lago de Kazhipally, ubicado en Medak (estado de Telangana). Ahora, incluso los más pobres aldeanos dicen que evitan acercarse al mismo. La razón estriba en que este estado sureño es el corazón del negocio de fabricación de antibióticos en el país, siendo uno de los mayores proveedores mundiales de los llamados "medicamentos baratos" para la mayoría de los mercados, informa 'Newsweek'. Solo las exportaciones de la ciudad de Hyderabad, capital del estado, suponen un ingreso de 14 millones de dólares anuales.
Activistas, investigadores y algunos empleados de las compañías farmacéuticas sostienen que la presencia de más de 300 empresas de fármacos, combinada con la falta de supervisión y un tratamiento inadecuado del agua, ha provocado que varios lagos y ríos queden infestados de antibióticos. Ello constituye un caldo de cultivo para la resistencia microbiana.
Amenaza del aumento de las 'superbacterias'
"Las bacterias resistentes se están reproduciendo aquí y afectarán a todo el mundo", alerta Kishan Rao, médico y activista que ha venido trabajando durante más de dos décadas en Patancheru, una zona industrial de Medak.
Mientras la contaminación de las tierras agrícolas es un problema grave para los habitantes que dependen de ellas para su sustento, la incubación potencial de estas 'superbacterias' en las vías fluviales de Medak tiene implicaciones más amplias: estas bacterias resistentes pueden infectar a las personas y pueden extenderse a través de los viajes.
El aumento del número de estas 'superbacterias' ha provocado la aparición en los últimos años de infecciones resistentes incluso a los antibióticos de última generación, reza el portal. Las autoridades sanitarias de EE.UU. advierten que las bacterias resistentes a los antibióticos causan 2 millones de infecciones graves y 23.000 muertes al año en el país norteamericano.